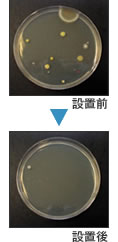

6
1.2×10
4
9.2×10
5
1.1×10
5
2.1×10
5
1.1×10
5
1.7×10
24時間後の菌数
食中毒の原因となる
抵抗力が弱っている人が感染すると様々の病院の原因となる
食中毒や化膿の原因となる
抵抗力の弱っている人が感染すると様々な病気の原因となる
大腸菌の中でも特に毒性が強い
食中毒の原因となる
菌の特徴
レジオネラ
MRSA
黄色ブドウ球菌
緑膿菌
大腸菌(O157:H7)
大腸菌
細 菌
5
3.3×10
米・野菜等の食料品に発生し腐敗を引き起こす
アオカビ
5
2.1×10
主に水周り、下駄箱、カーペット、ソファなどに発生する
クロカワカビ
5
2.1×10
24時間後の菌数
家の中で一番多くみられるカビ
カビの特徴
クロコウジカビ
カ ビ





検体(シーロマ)10mlをテドラーバックに入れ、空気ベースの検体を
封入した後、経時的に袋内の残存ガス濃度をガスクロマトグラフィー
で測定。なお、検体を入れずに同様な操作を行ったものを空実験と
した。

シーロマについて
取扱い商品
〒814-0121 福岡市城南区神松寺1-21-7-201
株式会社 リム・コーポレーション